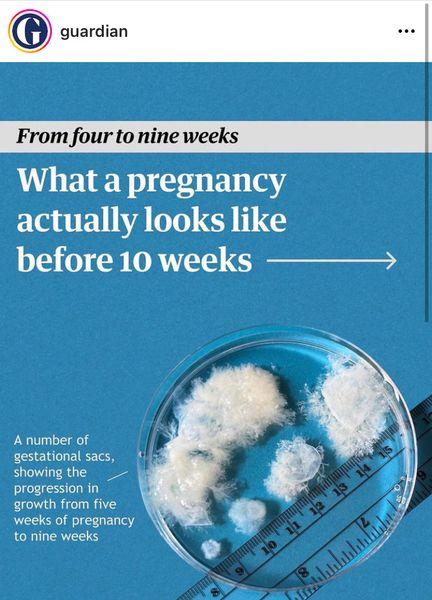
into-the-weeds

I also think it has to do with the stories we tell. And maybe that’s privilege too - the luxury of being able to choose stories for their excitement rather their accuracy, idk – but we don’t tell the stories of the miserable inches. Rosa Parks sat down, MLK made a speech, Obama was elected, and now racism is over – a nice, neat story in 3 acts that fits in a 2-hour time slot with time for commercial breaks.
We ignore the quiet heroism of a black woman deciding to use the white restroom so she can do her job properly, or a black man walking across Alabama because dammit he should be able to walk on a public road without danger. Of organizations patiently, repeatedly, steadfastly filing a lawsuit every single time someone tries to get away with something that’s illegal. Of one person getting their office building to separate compost from garbage, or organizing her apartment building on a rent strike, or taking one for the team to say “that’s kinda sexist don’t you think?” when his boss commits a microaggression in a meeting. We don’t talk about writing to your city council every single time police overstep their authority, or paying attention to which textbooks the school board is selecting, or sharing art from POC creators.
So when you finally wake up and recognize your privilege and think “Holy shit! Women’s lives are harder for the stupidest reasons!” or “Oh My God, racism is out of control in this country!” or “Damn, my life woulda sucked if my parents hadn’t been able to pay for my college” or “Fuck, capitalism may have some impressive accomplishments under its belt but holy crap is unrestrained capitalism deadly!” or whatever, and you decide you can’t live with it anymore, and you’re going to do something about it, what do you think of?
Harry Potter. Les Miserables. Mockingjay. I am either going to die on the battlefield in glory or rise up.
And when that’s the only story you know, it looks like the only option. Revolution or acceptance. Anyone who says “Guys, we should at least have a plan before we violently overthrow the government” is a collaborator and a quisling because this has been going on too long and change can’t wait. And like, you’re right. This HAS been going on too long and change CAN’T wait. We should not do nothing. But revolution is not the only something that can happen.
IDK, this kinda got away from me. I only know that I’ve been trying since June to figure out what a soft-spoken nerd can do as activism, and there is no answer out there. Meaningless symbolism, passive acceptance, and violent revolution are the only categories of advice I can find.